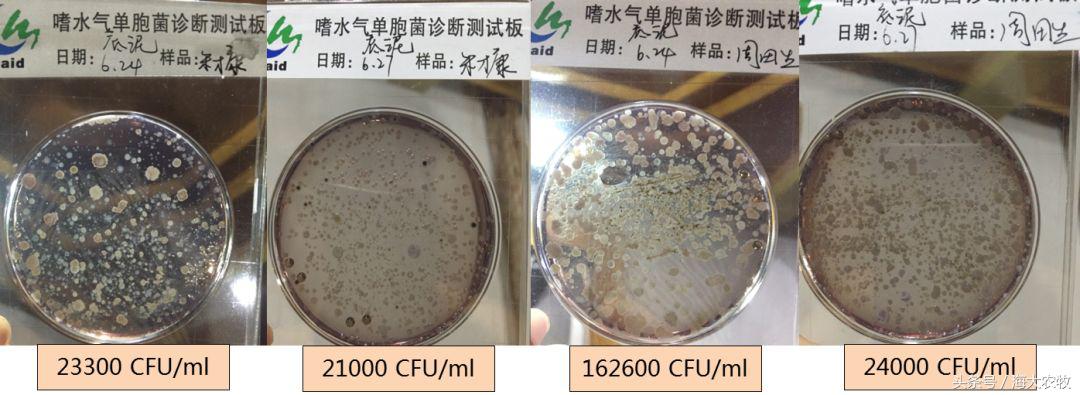
变天鱼起浮,变天鱼都浮水面怎么回事
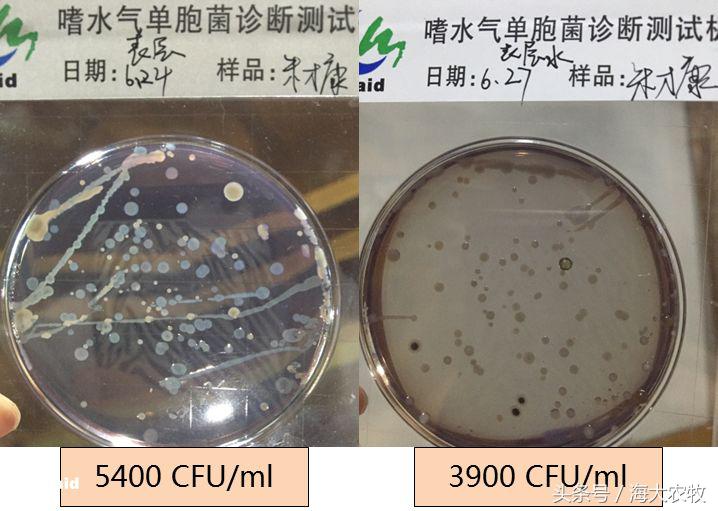
变天鱼起浮,变天鱼都浮水面怎么回事

文 | 图 常州海大 刘颂涛、动保与服务中心 曾宇鲲
江南进入梅雨天气后,鳊鱼的发病随之而至,截止目前鱼塘发病率高达95%,死亡率1-5%,而且一遇到变天的时候死鱼数量增加。今年7-8月份依然阴雨天气居多,面对这样的天气该如何应对呢?
一、养殖问题及原因分析
朱老板养殖面积80亩,放养鳊鱼17万尾,截止到6月19日,池塘总共死鱼300尾,但是6月23号变天后,6月24日一天死鱼高达500尾,询问其周边塘口发现相同的现象。
通过检测发现,变天后鱼塘的主要变化在于溶氧降低和嗜水气单胞菌数量上升。嗜水气单胞菌数量由2500 CFU/ml 低致病浓度上升到4000 CFU/ml 以上的高致病浓度。

为什么阴雨后池塘
嗜水气单胞菌数量递增?
通过4-6月份的病菌数据积累发现,天气稳定时中下层水中嗜水气单胞菌数量是中上层水的1.2-1.5倍,但是遇到天气变化即雨后转晴或转阴,中下层水体中的病菌数量大幅上升,达到表层水的4-6倍。加之梅雨期间,上下水层对流,底泥中病菌释放到水体中。
底泥的危害
1、产生硫化氢、亚盐、氨氮等常见的有毒有害物质不断的向水体中释放;
2、淤泥中的有机质在分解过程中不断消耗水体中的氧分,遇到大风 、大雾 、阴雨 、雷阵雨等气压偏低的不良气侯,就会造成池塘鱼类因严重缺氧浮头 、泛塘 ,严重者全塘死鱼的事时有发生 。
3、为寄生虫、病原微生物的生长繁殖提供营养条件造成病原微生物数量大量上升,成为有害微生物的避难所和滋生场。所以梅雨天的时候发现寄生虫和病菌增多。
鳊鱼主要活动在中下层,底部致病菌数量上升,将致使本来体质差的鱼发病死亡。所以天气变化时嗜水气单胞菌数量提升,导致鳊鱼死亡量上升。
二、改底能不能让鱼病好转?

朱老板在6月25号使用底倍健2亩/包,死鱼数量5天内逐渐下降至个位数。
而其周边一同样发病塘口未改底,死鱼数量一直持续不减:50亩放养13万鳊鱼,同期日死亡鳊鱼300-500尾不等,造成日经济损失>300尾*0.6斤/尾*4元/斤=720元。
三、为什么改底可以让鱼病好转?
01
改底前后底泥颜色的变化

改底前底泥浓稠发黑发臭,改底后表层2cm底泥松软颜色变淡黄色

经常改底塘口,采底泥看到表层2-3cm底泥淡黄色,底部底泥结成硬块。而不改底的塘口,底泥发黑发臭,5-10cm松散。
02
改底前后氧化还原电位的变化

单次改底后ORP由-211mv提升至-122mv,净增长42%。
03
改底前后水体中
嗜水气单胞菌数量变化
未改底组嗜水气单胞菌数量变化
改底组嗜水气单胞菌数量变化
(1)改底组:改底前后无论是中上层水体还是底泥中的嗜水气单胞菌数量都在下降,下降比例分别27%和10%。
(2)未改底组:同期检测,发现相同取样位点嗜水气单胞菌的数量提升47.6%。
04
底层水质指标的变化

底泥中微生物呼吸产生二氧化碳和有机酸,使底泥pH偏酸性,长期缺氧的底泥其酸化程度更高,有利于致病菌增殖。改底后,底层水pH得到提升,既能抑制病原菌繁殖,又能够促进磷、钾等营养元素的释放。
通过检测改底前后以上指标的变化 ,证明改底能够通过提升底泥ORP和底部pH,降低病原菌的数量,从而减少死鱼数量。
四、梅雨及高温的改底策略
梅雨及高温阶段未改底池塘底泥ORP范围:-200mv—-400mv,而底泥ORP安全范围需>-100,单次改底即可达到安全范围。但由于该阶段投喂增加,水温上调,底质恶化速率加快,为保障鳊鱼健康养殖,建议持续多次改底并配合消毒,确保塘底底质与病原数量长期稳定在安全范围内,降低发病风险。
具体方案如下:
1、改底产品的选择
连续阴雨天建议选择增氧型的底倍健或3202,两种交换使用,同时在改底后配合二氧化氯进行消毒。连续晴天使用底倍康+底倍健/3202促进底泥有机质的分解,消耗氧债,释放营养。
2、改底产品用量
底倍健和3202按水面计算,用量分别为2亩/包,8-10亩/包。在食台、增氧机附近增加使用量。
3、改底频率
由于7-9月份为投喂高峰期,每天有大量的残饵粪便排泄沉积到底部,超过池塘自净能力,所以底改频次为10天/次。
4、使用时机
变天前一天进行改底,平时正常天气最后一餐结束后改底。
常州海大精彩文章
- 我不是药神,但是我能让发病率降低70%!
- 注意!梅雨期投喂不当,一亩黄颡鱼损失可能超400元!
- 老死鱼怎么办?鱼病防控新思路!仅靠消毒内服是远远不够的
- 鲈苗期驯化,这个操作让你的成活率提高15.8%
- 同缸对比,海大鳊鱼华海1号抗逆性超强!养殖户在塘头亲眼见证
- 鱼健乐解密:草鱼钢铁侠是如何炼成的!
- 如果黄颡鱼消化吸收能力提升1倍!是不是1斤饲料可以当2斤用?
- 海大鲈鱼苗,成活率99%!养殖“核*器武**”,拿早苗,抢先机!
- 10天长1两,系数1.3,鱼健乐为存塘鳊鱼保“价”护航
- 立马见效!泼洒鱼多宝发酵液,有害菌最高减少53.3%
- 养殖利器!一个发酵桶,解决黄颡鱼三大难题
- 大普查!早春黄颡鱼肝肠问题达93.7%,存塘鱼没有你想像中的健康
- 鲈鱼苗塘将爆发熟身病,怎么办?请做好这三步!
- 神奇!塘头一线数据告诉你,鲈鱼内服肝肠利健的惊人效果
- 厉害!套养海大全雄黄颡鱼苗,白鱼亩效益瞬间多了1300多元!
- 海大鱼健乐效果劲爆,饲料转化效率提升50%!——兵哥压片法,让饲料消化肉眼看得见
转载声明
本文版权属于海大农牧
未经授权,一律禁止转载!
文章投稿、转载授权,欢迎发邮件到:
haidnm@haid.com.cn